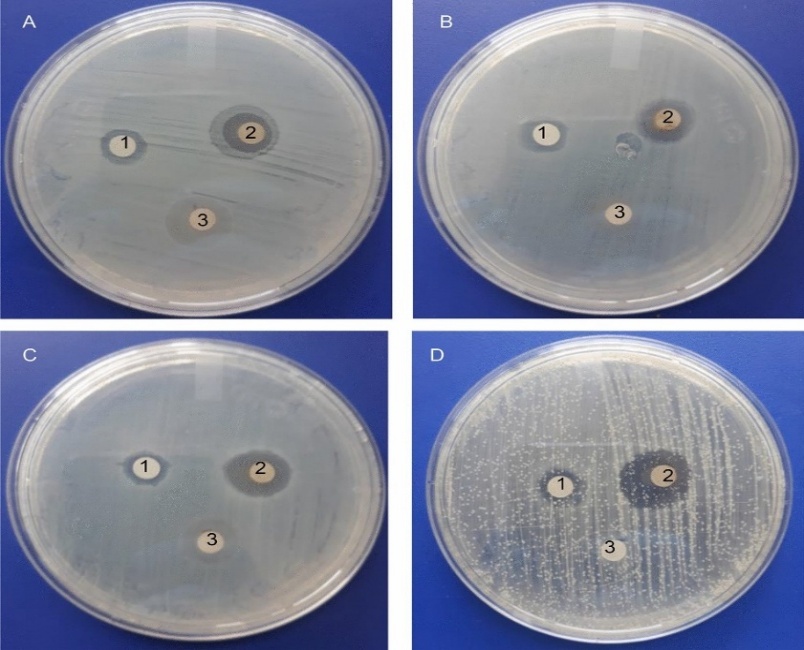

We use cookies to ensure our website works properly and to personalise your experience. Cookies policy

We use cookies to ensure our website works properly and to personalise your experience. Cookies policy
Department of Pharmacognosy, JES’s SND College of Pharmacy, Babhulgaon (Yeola), India
As medical science advances, the field of wound care is constantly evolving. However, experts in this area continue to face numerous challenges in finding the perfect dressing material. With the rise of multi-resistant organisms and the decreasing effectiveness of modern antibiotics, wound care professionals are revisiting traditional and alternative healing methods. It’s encouraging to see that public perception of traditional medicine is improving. In this study, ointments were developed after analyzing the effectiveness of plant extracts in promoting wound healing. Palash, Bael, and Honey have been selected for this study as herbal plants known for their benefits. Ethanol was utilized to extract specific dried components from these plants. Various evaluation techniques were employed to assess the quality of the resulting products. The physical attributes of the formulations remained stable, and the pH level was maintained around 7, which is considered acceptable. Throughout the study, the formulations exhibited good consistency and favorable spreadability. It was noted that the viscosity of the ointment decreased with an increase in the rate of shear (rpm), indicating that lower shear rates resulted in higher viscosity. The ointment was easy to wash off with water, showed no signs of skin irritation, and there was no degradation in the ointment sample. This study suggests that ointments containing herbal extracts with potential wound-healing properties can be effectively formulated and utilized to create a protective barrier for the skin.
Introduction of Ointment:
Ointments are a specific form of topical medication, typically composed of a semi-solid mixture of medicinal substances and a base, which often consists of hydrocarbons, alcohols, or fatty acids. They are designed to be applied directly onto the skin or mucous membranes to provide localized therapeutic effects and can also serve systemic purposes when absorbed through the skin. Ointments are semisolid formulations that typically exhibit viscoelastic properties when subjected to shear stress. These preparations often incorporate active pharmaceutical ingredients and are designed for external application on the skin or mucous membranes. Non-medicated ointments, which are often called ointment bases, serve as the foundation for creating medicated ointments or can be utilized on their own for their soothing or lubricating properties. In the context of prescription practices, different terminology is frequently applied to describe a variety of similar products, such as creams, pastes, and cerates, which may also have emollient functions [1,2]. Numerous medications intended for topical use on intact or damaged skin, as well as mucous membranes, are formulated into semisolid forms, which are commonly referred to as ointments, creams, salves, and pastes. These products primarily serve as protective or emollient agents for the skin. Contemporary ointments fulfill this role while also facilitating the absorption of medications into the bloodstream. As such, they are categorized as follows:
a) Epidermatic - Designed for action on the outer layer of the skin (epidermis).
b) Endodermatic - Tailored for effects on the deeper layers of the skin's tissues (cutaneous tissues).
c) Diadermic - Intended to penetrate deeply and release medications into the body's fluids, contributing to systemic circulation.
All ointments contain a base that primarily serves as a carrier for the active ingredients. The characteristics of the base significantly influence the effectiveness of the ointment. Therefore, choosing the appropriate ointment base is a crucial element in the formulation process. To comprehend the mechanisms of percutaneous absorption of ointment bases, it is important to have a good understanding of skin structure and its relationship to drug absorption [3]. Herbal medications can also be formulated as ointments. The process begins with the preparation of the ointment base, into which the active herbal ingredients are incorporated in optimal ratios through trituration. Once the formulation is complete, the quality of the ointment is evaluated based on parameters such as irritancy, spreadability, diffusion and stability [4]. Traditional medicine serves as a valuable source for discovering new compounds that may be developed into chemotherapeutic agents. The initial step in this discovery process is the screening of plants commonly used in traditional medicine. In addition to various dosage forms, herbal drugs may be prepared as ointments, which are viscous semisolid preparations intended for topical application to different body surfaces, including the skin and mucous membranes of the eyes, vagina, anus, and nose. Ointments may be medicated or non-medicated; medicated ointments include active ingredients that are dissolved, suspended, or emulsified within the base [5.6]. These ointments serve numerous topical purposes, such as acting as protectants, antiseptics, emollients, antipruritics, keratolytics, and astringents.
Wound and Wound Healing Process:
A wound refers to the disruption or damage to the structure or function of the skin or underlying tissue. It can occur due to various factors such as physical trauma, chemicals, heat, infections, or immune responses that affect the skin's integrity. Wounds not only harm the physical and psychological well-being of individuals but can also lead to significant costs and may result in permanent scarring. In broad terms, a wound is any injury that causes a break or opening in the skin [7]. Following skin injury or trauma, the healing process involves the contraction, migration, and reattachment of cells. Key processes in wound healing include platelet aggregation, clot formation, fibrin synthesis, inflammatory responses, alterations in ground substances, new blood vessel formation (angiogenesis), and re-epithelialization. For healing to be completed, collagen must firmly stitch the wound together, which eventually leads to scar formation. However, the presence of free radicals, which damage surrounding tissue, can hinder the healing process. Additionally, several factors, such as infections, diet, medications, hormones, the type and location of the wound, and underlying health conditions, can influence how well and how quickly a wound heals [8-11].
Ayurvedic medicines for wound healing:
Palash (Butea monosperma)

Butea monosperma
Synonym: Tripatra, Kimshuka, Kharaparna, Palash, Ksharashrestha.
Family: Fabaceae.
Biological Source: Butea monosperma is a species of Butea native to tropical and sub-tropical parts of South Asia and Southeast Asia. It is also known as flame of the forest, Bengal kino, dhak, palash, and bastard teak.
Geographical source: The Butea monosperma Lam. Kuntze is the botanical source of Palash. This medium-sized deciduous tree can be found all over the northern region of India. Palash, also referred to as "flame of the forest," is a member of the Fabaceae family. Butea monosperma Lam., commonly known as the Flame of the Forest, belongs to the subfamily Caesalpinioideae in the Fabaceae family (formerly Leguminosae). It is referred to as "Palash tree" in India and is found across India and the South Asian peninsula. There are four varieties of Palash: Rakta (red), Pita (yellow), Shweta (white), and Nila (blue), as mentioned by Narahari in the Raj Nighantu. Among these, Shweta and Nila are rare, and Pita is considered endangered. Due to the scarcity of the Pita variety, the commonly available Rakta variety is used extensively in medicine and is often called the Flame of the Forest. This plant holds great significance in Vedic rituals, particularly in Yajna (sacred fire ceremonies). In India, it is used in the worship of deities and plays a role in various festivals. Ayurveda, the ancient science of life, associates specific scientific principles with the use of plants for medicinal purposes, and many festivals are rooted in these practices [12-14].
Bael Leaf (Aegle Marmelos)

Aegle Marmelos
Synonym: Bilav, shandliya, shailush, maloor and shriphal
Biological source: (Aegle marmelos L.). It belongs to the family of Rutaceae. It grows in India, Bangladesh, Ceylon, Thailand, and Indo-China (Parichha, 2004). Is a medium-sized deciduous tree cultivated in India with the common name “Bael” or “Wood apple.”
Geographical Soure: Bael [Aegle marmelos (L.) Correa] is native to India and is widely distributed throughout the country in 8 states such as Uttar Pradesh, Bihar, West Bengal, Rajasthan, Madhya Pradesh, Uttaranchal, Chhattisgarh and Odisha Aegle marmelos (Rutaceae) is a medium-sized, slender, aromatic tree that typically grows to a height of 6.0-7.5 meters and has a girth of 90-120 cm. It is commonly found in the deciduous forests of India. In contrast, the ripe fruit is sweet, aromatic, and cooling. The unripe fruit is known for its astringent, digestive, and stomachic qualities, making it helpful in treating diarrhea and dysentery. The root of the tree is sweet and has medicinal properties, helping to treat fever, abdominal pain, heart palpitations, and urinary issues. The extracted from the leaves is used to treat eye infections The leaves are also applied externally to heal wounds, boils, and cuts. Due to its traditional use in wound healing, a study was conducted to assess the wound-healing effects of an extract from Aegle marmelos [14-16].
Honey (Apis mellifera, Madhu)

Apis mellifera
Synonym: Apis mellifera, honey purified, Mel
Family: The honey bees belong to the Apidae family.
Biological Source: Honey is sugar secretion deposited in honey comb by the bees, Apis mellifera, Apis dorsata, and other species of Apis.
Geographical Source: Honey is produced in India and major produce comes from the state of Himachal Pradesh & Other chief countries are Australia, New Zealand, USA (California), dermis, and hypodermis) and serves as the body's primary physical defense against external pathogens. Wounds are defined as breaks in the skin’s continuity caused by mechanical, chemical, or thermal damage, leading to a loss of its protective functions. The goal of the wound-healing process is to restore the integrity of the damaged tissue and regenerate the lost epithelium. It is a dynamic and intricate process that occurs in four overlapping stages: hemostasis, inflammation, tissue proliferation, and regeneration. In the inflammatory phase, hemostasis, chemotaxis, and increased vascular permeability help prevent additional damage, close the wound, clear away cellular debris and bacteria, and encourage cell migration [17-19].
Table 1: Formulation table and their roles
|
Ingredients |
Quantity(g) |
Roles |
|
Palash extract |
1gm |
Antimicrobial, wound healing. |
|
Bael extract |
1gm |
Antioxidant, Anti--inflammatory |
|
Honey |
1gm |
Natural humectant, Antimicrobial |
|
Bee’s wax |
1.5gm |
Ointment base, Skin protective barrier |
|
Soft paraffin |
2.0gm |
Emollient, base for ointment |
|
Liquid paraffin |
1.5ml |
Softening agent, improves spreadability |
|
Vitamin E oil |
0.5ml |
Antioxidant, skin regeneration |
|
Methyl Paraben |
0.2ml |
Preservative |
|
Rose oil |
0.3ml |
Fragrance |
|
water |
1.0ml |
|
METHODS:
Collection of plants material:
In the local botanical garden, Palash and Bael were harvested. It is widely accepted that the optimal time to collect medicinal plants is when they contain the highest levels of their active compounds, which is true regardless of the type of plant or the location of the harvest. Additionally, current environmental conditions play a significant role in the harvesting of these natural remedies. When it comes to large-scale collection of herbal drugs, it's crucial to prioritize the use of a skilled workforce. For instance, rhizomes should be harvested when they have an adequate reserve of nutrients and exhibit the highest concentration of their beneficial chemical components [20,21].
Extraction process:
Technique: Soxhlet apparatus
The crude leaves of Palash and Bael were subjected to solvent extraction to eliminate coloring agents, utilizing a defatting process through the continuous Soxhlet extraction method. Following the complete defatting, the resulting powder was treated with a solvent for a duration of 11 to 12 hours. The extraction was conducted at a controlled temperature ranging from 40- 450C. After the extraction process, the solution was evaporated and concentrated to form a thick consistency, which was then freeze-dried to obtain a semi-solid form. The final extract was stored in an airtight container to maintain its quality [22-24].


Figure 1: Palash and Bael extraction
Procedure for Preparing Water-in-Oil (W/O) Ointment:
Evaluation:
1)Organoleptic Properties:
Color, Odour and appearance of ointments was examined by visual examination.
2) Consistency:
Smooth and no greediness is observed.
3) PH:
The pH of ointment formulation was determined by using digital pH meter. 1gm of ointment was dissolved in 100 ml of distilled water and stored for two hours. The measurement of pH of each formulation was done in triplicate and average values were depicted. Dukare S, Gaikwad P, Kolhe S, Jadhav SL. Formulation and evaluation of polyherbal ointment. American Journal of Pharmtech Research, 2017; 7(6): 62-70.
4) Spreadability Test:
Spreadability is expressed in terms of time in seconds taken by two slides. To flip out or from Ointment when placed in between the slides under the direction of certain load. Laser the time taken for separation of two slides, better the spread ability.
It is calculated by using the formula. S = M x L/T,
were,
M = Weight tied to upper slide,
S = Spread ability of formulation,
L = Length of Glass Slides,
T = Time taken to separate the slides.
5) Viscosity:
The apparent viscosity values of the ointment formulations were measured using a Brookfield viscometer with spindle no. 6 at room temperature and 50 rpm using the standard operating procedure as directed in the manufacturer manual.
6) Washability:
The washability of the Herbal formulations was determined by applying the ointments over the skin and the extent of easy washing with distilled water was manually observed.
7) Non-irritancy test:
Herbal ointment prepared was applied to the skin of human being and observed for the effect. The test is performed by applying the small amount sample to the hand and observed for 24hours to check the effect like redness, erythema, inflammation etc. Hence, no such effect was observed, it is nonirritant to the skin.
8) LOD:
LOD was determined by placing the formulation in Crucible on Hot air oven and dried for the temperature 105oC.
9) Solubility:
Soluble in boiling water, miscible with alcohol, ether, chloroform [26].
Pharmacological activity:
Antimicrobial activity:
1) Prepare nutrients agar medium and sterilize by autoclave at 121°c for 15 minutes.
2) Prepare the agar plate and label with the name of microorganisms inoculated using sterile technique inoculated agar plate with their respective test microorganisms by swab streak method or spread plate method.
3) Allow all culture plate to dry about skin using sensifies dispenser apply the antibiotics disc by placing dispenser over the agar surface.
4) If dispenser is not available distribute the individual disc at equal distance with sterile forceps.
5) Gently press each disc down with wooden end of cotton swap or sterile forceps. that the disc adheres to surface of agar the agar.
6) Incubate all plate in inverted position at 37° for 24-48 hr [27,28].
Figure 2: Agar media
RESULT AND DISCUSSION:
The herbal wound healing ointment presents several notable physical characteristics: it has a brownish color, a mild and pleasant aroma with herbal notes, and a greasy yet smooth texture. The ointment is in a semisolid state, exhibiting a smooth consistency without any greasiness. Its pH level is measured at 7. The spreadability is quite good, allowing for easy application, and it can be effortlessly washed off with water. Additionally, the ointment is non-irritating to the skin and does not experience any loss due to drying. It shows good solubility in boiling water and is miscible with alcohol, chloroform, and ether. The viscosity of the ointment is recorded at 7500 cP.
CONCLUSION:
Throughout ancient history, Palash, Bael, and Honey have been recognized for their numerous medicinal benefits, including antibacterial, antifungal, and anti-inflammatory properties. This ointment formulation aims to harness these therapeutic characteristics, providing an effective and convenient dosage form for topical application. Test results indicate that the ointment can be applied externally to protect the skin from damage and enhance its healing effects.
Additional improvement:
I have tested this ointment's effect on a wound in contract with skin cells, which may cause itching. Next time, I plan to improve the ointment by adding coconut oil for its lubricating effect. I did not add coconut oil this time because the evaluation parameters of the ointment had already.
REFERENCES



Kavita Sharma*, Tejas Anarthe, Rushikesh Wakalkar, Formulation and Evaluation Herbal Wound Healing Ointment, Int. J. of Pharm. Sci., 2025, Vol 3, Issue 5, 01-10. https://doi.org/10.5281/zenodo.15313993
 10.5281/zenodo.15313993
10.5281/zenodo.15313993